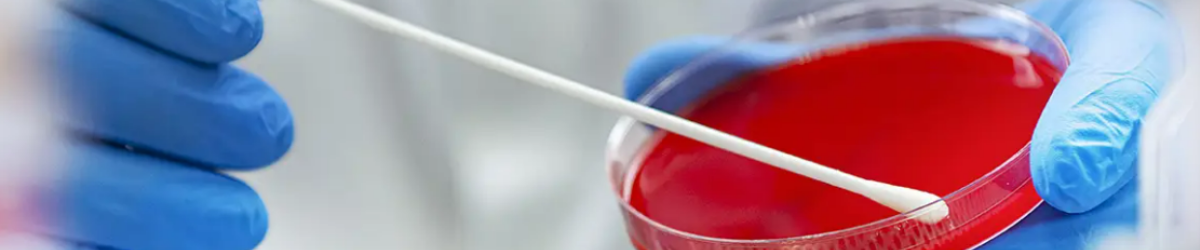
ClassiqswabFoto2-strona001.png

-
Koszyk jest pusty
-
x
Do bezpłatnej dostawy brakuje
-,--
Darmowa dostawa!
Suma
0,00 zł
Cena uwzględnia rabaty
Sklep tylko dla profesjonalistów z branży medycznej! Przechodząc dalej potwierdzasz, że posiadasz odpowiednie kwalifikacje zawodowe.
0
twój koszyk
0,00 zł
-
Koszyk jest pusty
-
x
Do bezpłatnej dostawy brakuje
-,--
Darmowa dostawa!
Suma
0,00 zł
Cena uwzględnia rabaty